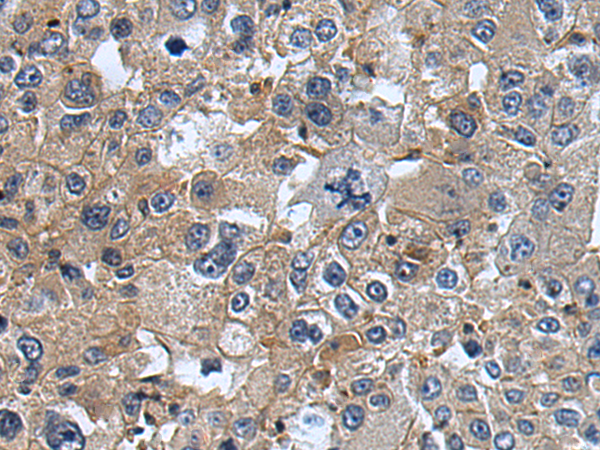

中文名稱: 兔抗UBA7多克隆抗體
|
Background: |
The modification of proteins with ubiquitin is an important cellular mechanism for targeting abnormal or short-lived proteins for degradation. Ubiquitination involves at least three classes of enzymes: ubiquitin-activating enzymes, or E1s, ubiquitin-conjugating enzymes, or E2s, and ubiquitin-protein ligases, or E3s. This gene encodes a member of the E1 ubiquitin-activating enzyme family. The encoded enzyme is a retinoid target that triggers promyelocytic leukemia (PML)/retinoic acid receptor alpha (RARalpha) degradation and apoptosis in acute promyelocytic leukemia, where it is involved in the conjugation of the ubiquitin-like interferon-stimulated gene 15 protein. |
|
Applications: |
ELISA, IHC |
|
Name of antibody: |
UBA7 |
|
Immunogen: |
Fusion protein of human UBA7 |
|
Full name: |
ubiquitin-like modifier activating enzyme 7 |
|
Synonyms: |
D8; UBE2; UBA1B; UBE1L |
|
SwissProt: |
P41226 |
|
ELISA Recommended dilution: |
5000-10000 |
|
IHC positive control: |
Human lung cancer and human esophagus cancer |
|
IHC Recommend dilution: |
30-150 |

購物車
幫助
021-54845833/15800441009
